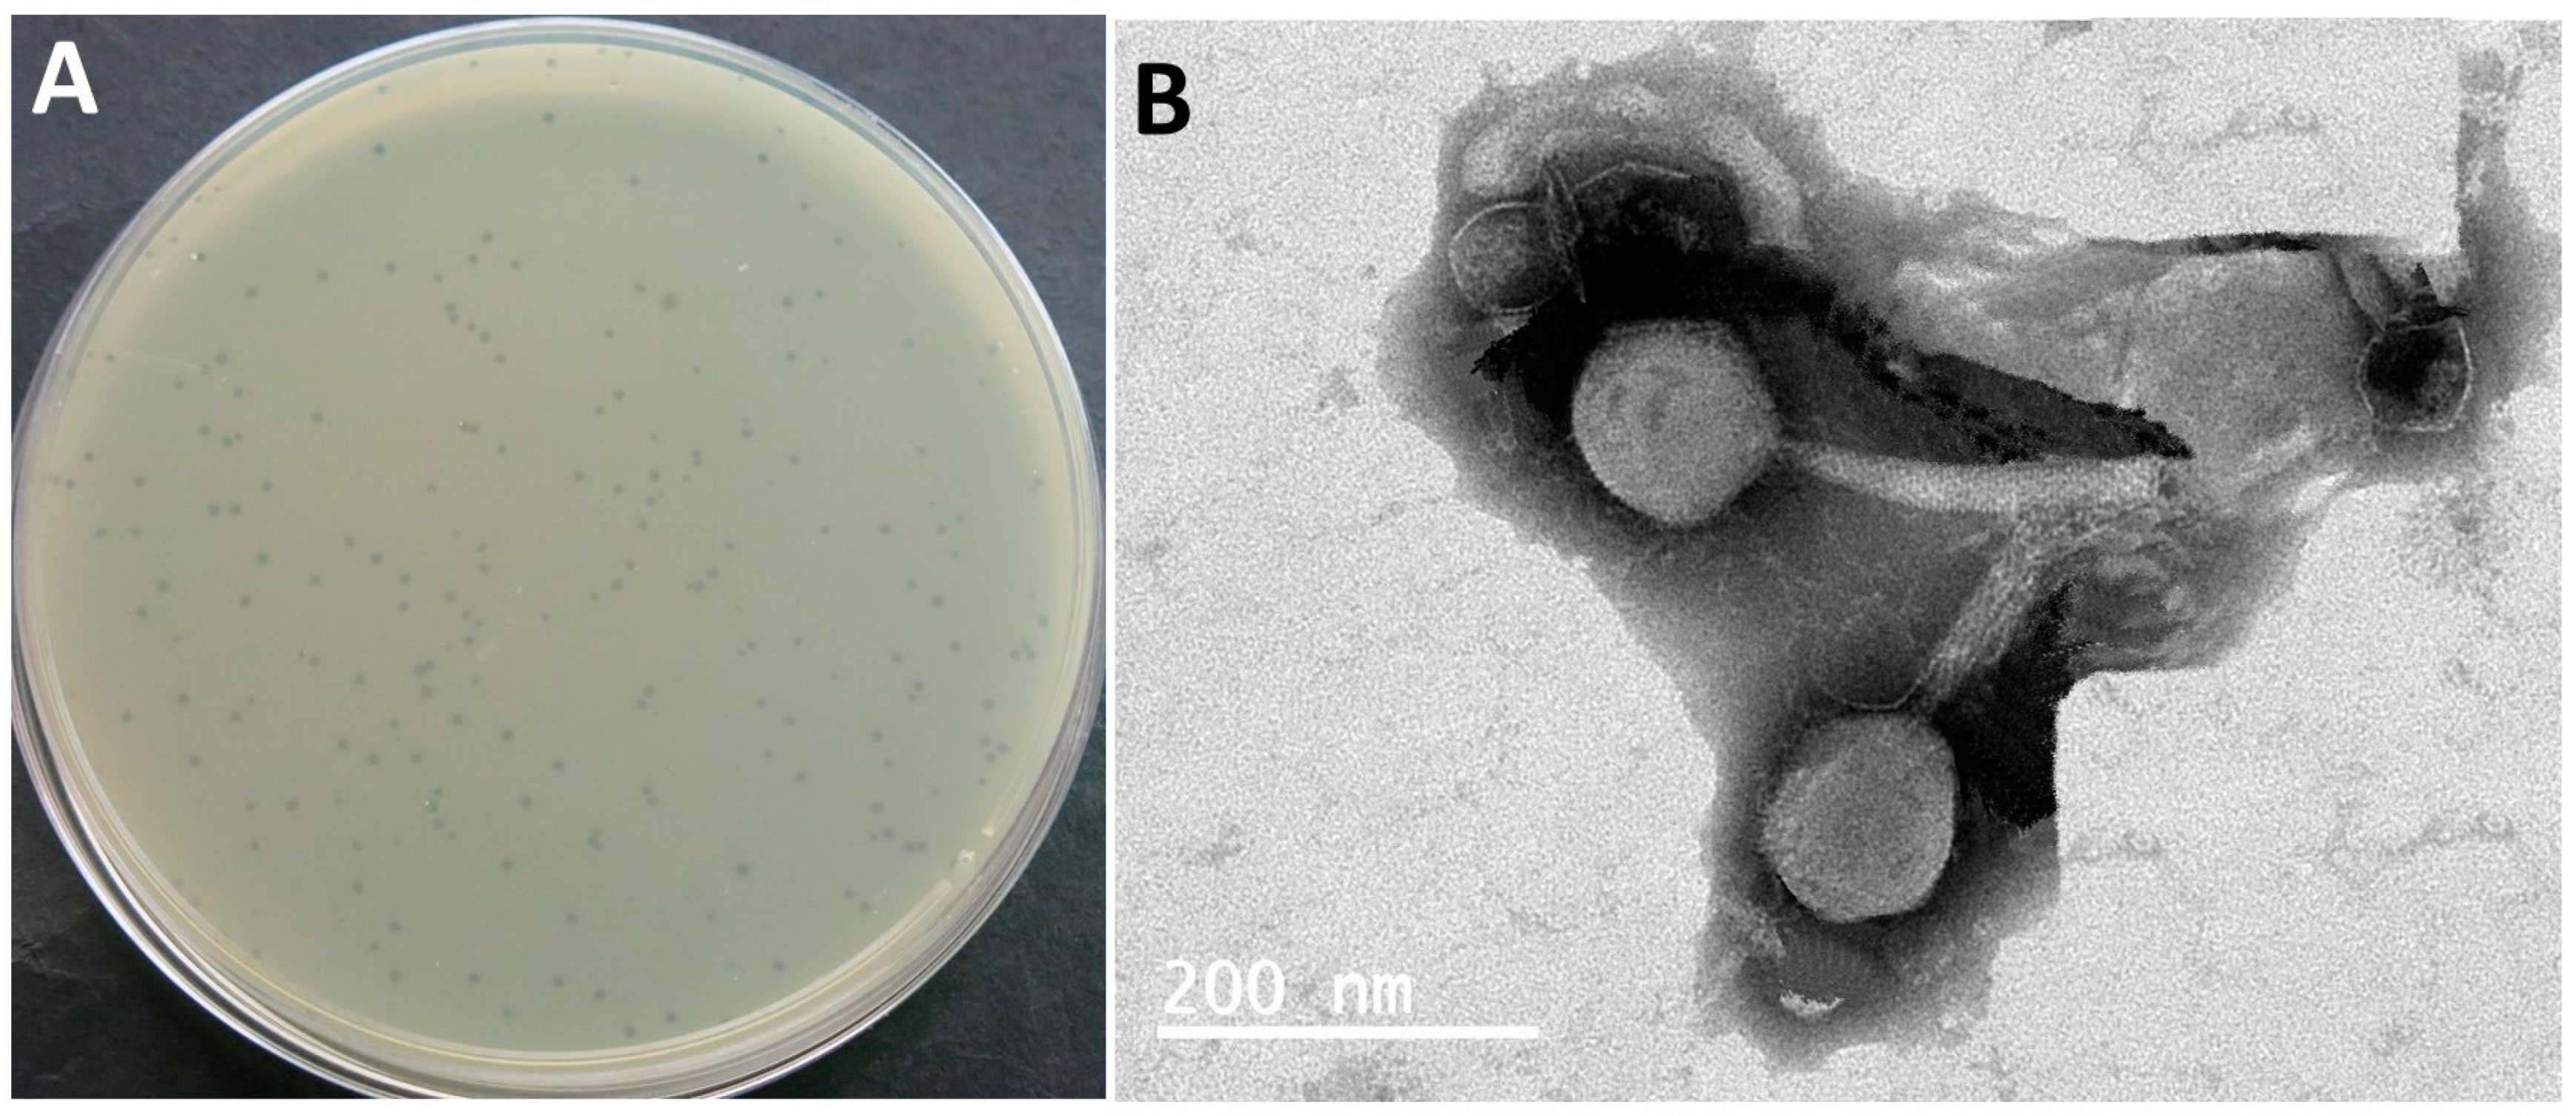
Biomedicines 12 02036 g001 Biomedicines 12 02036 g001

Isolation and Characterization of Novel Escherichia coli O157:H7 Phage SPEC13 as a Therapeutic Agent for E. coli Infections In Vitro and In Vivo
Abstract
1. Introduction
2. Materials and Methods
2.1. Bacteria Strains and Growth Conditions
2.2. Phage Isolation and Purification
2.3. Lytic Spectrum Determination by Spot Test
2.4. Determination of Host Range by Efficiency of Plating (EOP)
2.5. Transmission Electron Microscopy (TEM) of SPEC13
2.6. Absorption Kinetics and One Step Growth Curve of Phage SPEC13
2.7. Temperature and pH Tolerance of Phage SPEC13
2.8. Phage SPEC13 Genome Sequencing, Annotation and Comparison
2.9. Phage Infection Assay through Challenge Testing
2.10. In Vivo Investigations
2.11. Statistical Analysis
3. Results
3.1. Isolation and Characterization of the Phages
3.2. Spot Test and EOP Assay
3.3. One-Step Growth Curve of SPEC13
3.4. pH and Thermal Stability
3.5. SPEC13 Is a Newly Discovered Phage Belonging to an Unknown Genus
3.6. Lytic Activity of Phage SPEC13 In Vitro
3.7. Inhibition Effect of Phage SPEC13 on E. coli O157:H7 in LB Medium
3.8. Effect of Phage on Body Weight and Colon Length
3.9. Effect of SPEC13 on Fecal Microbe
4. Discussion
5. Conclusions
Supplementary Materials
Author Contributions
Funding
Institutional Review Board Statement
Informed Consent Statement
Data Availability Statement
Conflicts of Interest
References
- Othman, S.M.; Sheet, O.H.; Alsanjary, R.A. Isolation and identification of Escherichia coli O157:H7 isolated from Veal Meats and Butchers’ Shops in Mosul city, Iraq. J. Appl. Vet. Sci. 2022, 7, 55–61. [Google Scholar]
- Kolodziejek, A.M.; Minnich, S.A.; Hovde, C.J. Escherichia coli 0157:H7 virulence factors and the ruminant reservoir. Curr. Opin. Infect. Dis. 2022, 35, 205–214. [Google Scholar] [CrossRef] [PubMed]
- Zhang, Y.; Zou, G.; Islam, M.S.; Liu, K.; Xue, S.; Song, Z.; Ye, Y.; Zhou, Y.; Shi, Y.; Wei, S.; et al. Combine thermal processing with polyvalent phage LPEK22 to prevent the Escherichia coli and Salmonella enterica contamination in food. Food Res. Int. 2023, 165, 112454. [Google Scholar] [CrossRef] [PubMed]
- Lim, J.Y.; Yoon, J.; Hovde, C.J. A brief overview of Escherichia coli O157:H7 and its plasmid O157. J. Microbiol. Biotechnol. 2010, 20, 5–14. [Google Scholar] [CrossRef] [PubMed]
- Hossain, M.M.K.; Islam, M.S.; Uddin, M.S.; Rahman, A.T.M.M.; Ud-Daula, A.; Islam, M.A.; Rubaya, R.; Bhuiya, A.A.; Alim, M.A.; Jahan, N.; et al. Isolation, Identification and Genetic Characterization of Antibiotic Resistant Escherichia coli from Frozen Chicken Meat Obtained from Supermarkets at Dhaka City in Bangladesh. Antibiotics 2023, 12, 41. [Google Scholar] [CrossRef] [PubMed]
- Munns, K.D.; Selinger, L.B.; Stanford, K.; Guan, L.; Callaway, T.R.; McAllister, T.A. Perspectives on super-shedding of Escherichia coli O157:H7 by cattle. Foodborne Pathog. Dis. 2015, 12, 89–103. [Google Scholar] [CrossRef] [PubMed]
- Ma, J.; Ibekwe, A.M.; Yi, X.; Wang, H.; Yamazaki, A.; Crowley, D.E.; Yang, C.H. Persistence of Escherichia Coli O157:H7 and Its Mutants in Soils. PLoS ONE 2011, 6, e23191. [Google Scholar] [CrossRef] [PubMed]
- Alam, M.J.; Zurek, L. Association Of Escherichia coli O157:H7 with Houseflies on a Cattle Farm. Appl. Environ. Microbiol. 2004, 70, 7578–7580. [Google Scholar] [CrossRef] [PubMed]
- Klous, G.; Huss, A.; Heederik, D.J.J.; Coutinho, R.A. Human–livestock contacts and their relationship to transmission of zoonotic pathogens, a systematic review of literature. One Health 2016, 2, 65–76. [Google Scholar] [CrossRef]
- Ariyanti, T.; Rachmawati, F.; Noor, S.M.; Suhaemi. Contamination of Escherichia coli O157:H7 in Milk and Its Dairy Products in Depok, Cianjur, Sukabumi and Bandung. IOP Conf. Ser. Earth Environ. Sci. 2022, 1107, 012047. [Google Scholar] [CrossRef]
- Sancak, Y.C.; Sancak, H.; İşleyici, Ö.; Durmaz, H. Presence of Escherichia coli O157 and O157:H7 in raw milk and Van herby cheese. Bull. Vet. Inst. Pulawy 2015, 59, 511–514. [Google Scholar] [CrossRef]
- Bull, M.B.; Cohen, C.A.; Leung, N.H.L.; Valkenburg, S.A. Universally Immune: How Infection Permissive Next Generation Influenza Vaccines May Affect Population Immunity and Viral Spread. Viruses 2021, 13, 1779. [Google Scholar] [CrossRef]
- Brás, A.; Braz, M.; Martinho, I.; Duarte, J.; Pereira, C.; Almeida, A. Effect of Bacteriophages against Biofilms of Escherichia coli on Food Processing Surfaces. Microorganisms 2024, 12, 366. [Google Scholar] [CrossRef]
- Ariyanti, T.; Noor, S.M.; Suhaemi; Rachmawati, F. Antimicrobial Resistance Pattern of Escherichia coli O157:H7 Isolated from Cattle in West Java, Indonesia. IOP Conf. Ser. Earth Environ. Sci. 2022, 1107, 012048. [Google Scholar] [CrossRef]
- Nart, P.; Naylor, S.W.; Huntley, J.F.; McKendrick, I.J.; Gally, D.L.; Low, J.C. Responses of Cattle to Gastrointestinal Colonization by Escherichia Coli O157:H7. Infect. Immun. 2008, 76, 5366–5372. [Google Scholar] [CrossRef]
- Arthur, T.M.; Bosilevac, J.M.; Brichta-Harhay, D.M.; Guerini, M.N.; Kalchayanand, N.; Shackelford, S.D.; Wheeler, T.L.; Koohmaraie, M. Transportation and Lairage Environment Effects on Prevalence, Numbers, and Diversity of Escherichia coli O157:H7 on Hides and Carcasses of Beef Cattle at Processing. J. Food Prot. 2007, 70, 280–286. [Google Scholar] [CrossRef]
- Grami, E.; Badawy, S.; Kiljunen, S.; Saidi, N.; Skurnik, M. Characterization and genome analysis of Escherichia phage fBC-Eco01, isolated from wastewater in Tunisia. Arch. Virol. 2023, 168, 44. [Google Scholar] [CrossRef]
- Yamaki, S.; Yamazaki, K.; Kawai, Y. Broad host range bacteriophage, EscoHU1, infecting Escherichia coli O157:H7 and Salmonella enterica: Characterization, comparative genomics, and applications in food safety. Int. J. Food Microbiol. 2022, 372, 109680. [Google Scholar] [CrossRef]
- Bumunang, E.W.; Zaheer, R.; Niu, D.; Narvaez-Bravo, C.; Alexander, T.; McAllister, T.A.; Stanford, K. Bacteriophages for the Targeted Control of Foodborne Pathogens. Foods 2023, 12, 2734. [Google Scholar] [CrossRef]
- Mizoguchi, K.; Morita, M.; Fischer, C.R.; Yoichi, M.; Tanji, Y.; Unno, H. Coevolution of Bacteriophage PP01 And Escherichia Coli O157:H7 in Continuous Culture. Appl. Environ. Microbiol. 2003, 69, 170–176. [Google Scholar] [CrossRef]
- Henrique, I.d.M.; Sacerdoti, F.; Ferreira, R.L.; Henrique, C.; Amaral, M.M.; Piazza, R.M.F.; Luz, D. Therapeutic Antibodies Against Shiga Toxins: Trends and Perspectives. Front. Cell. Infect. Microbiol. 2022, 12, 825856. [Google Scholar] [CrossRef]
- Zhang, Y.; Liao, Y.-T.; Salvador, A.; Sun, X.; Wu, V.C.H. Prediction, Diversity, and Genomic Analysis of Temperate Phages Induced from Shiga Toxin-Producing Escherichia coli Strains. Front. Microbiol. 2020, 10, 3093. [Google Scholar] [CrossRef]
- Islam, M.S.; Zhou, Y.; Liang, L.; Nime, I.; Liu, K.; Yan, T.; Wang, X.; Li, J. Application of a Phage Cocktail for Control of Salmonella in Foods and Reducing Biofilms. Viruses 2019, 11, 841. [Google Scholar] [CrossRef]
- Guo, Y.; Li, J.; Islam, M.S.; Yan, T.; Zhou, Y.; Liang, L.; Connerton, I.F.; Deng, K.; Li, J. Application of a novel phage vB_SalS-LPSTLL for the biological control of Salmonella in foods. Food Res. Int. 2021, 147, 110492. [Google Scholar] [CrossRef]
- Islam, M.S.; Hu, Y.; Mizan, M.F.R.; Yan, T.; Nime, I.; Zhou, Y.; Li, J. Characterization of Salmonella Phage LPST153 That Effectively Targets Most Prevalent Salmonella Serovars. Microorganisms 2020, 8, 1089. [Google Scholar] [CrossRef]
- Islam, M.S.; Zhou, Y.; Liang, L.; Nime, I.; Yan, T.; Willias, S.P.; Mia, M.Z.; Bei, W.; Connerton, I.F.; Fischetti, V.A.; et al. Application of a Broad Range Lytic Phage LPST94 for Biological Control of Salmonella in Foods. Microorganisms 2020, 8, 247. [Google Scholar] [CrossRef]
- Islam, M.S.; Nime, I.; Pan, F.; Wang, X. Isolation and characterization of phage ISTP3 for bio-control application against drug-resistant Salmonella. Front. Microbiol. 2023, 14, 1260181. [Google Scholar] [CrossRef]
- Fister, S.; Fuchs, S.; Stessl, B.; Schoder, D.; Wagner, M.; Rossmanith, P. Screening and characterisation of bacteriophage P100 insensitive Listeria monocytogenes isolates in Austrian dairy plants. Food Control 2016, 59, 108–117. [Google Scholar] [CrossRef]
- Islam, M.S.; Yang, X.; Euler, C.W.; Han, X.; Liu, J.; Hossen, M.I.; Zhou, Y.; Li, J. Application of a novel phage ZPAH7 for controlling multidrug-resistant Aeromonas hydrophila on lettuce and reducing biofilms. Food Control 2021, 122, 107785. [Google Scholar] [CrossRef]
- Islam, M.S.; Raz, A.; Liu, Y.; Elbassiony, K.R.A.; Dong, X.; Zhou, P.; Zhou, Y.; Li, J. Complete Genome Sequence of Aeromonas Phage ZPAH7 with Halo Zones, Isolated in China. Microbiol. Resour. Announc. 2019, 8, e01678-18. [Google Scholar] [CrossRef]
- Kotwal, S.; Kaul, S.; Sharma, P.; Gupta, M.; Shankar, R.; Jain, M.; Dhar, M.K. De Novo Transcriptome Analysis of Medicinally Important Plantago ovata Using RNA-Seq. PLoS ONE 2016, 11, e0150273. [Google Scholar] [CrossRef]
- Zhang, M.; Qiu, X.; Zhang, H.; Yang, X.; Hong, N.; Yang, Y.; Chen, H.; Yu, C. Faecalibacterium prausnitzii Inhibits Interleukin-17 to Ameliorate Colorectal Colitis in Rats. PLoS ONE 2014, 9, e109146. [Google Scholar] [CrossRef]
- Almeida, A.; Cunha, A.; Gomes, N.C.M.; Alves, E.; Costa, L.; Faustino, M.A.F. Phage therapy and photodynamic therapy: Low environmental impact approaches to inactivate microorganisms in fish farming plants. Mar. Drugs 2009, 7, 268–313. [Google Scholar] [CrossRef]
- Hallajzadeh, M.; Mojtahedi, A.; Amirmozafari, N.; Pirhajati Mahabadi, V. Characterizing a Lytic Bacteriophage Infecting Methicillin-Resistant Staphylococcus aureus (MRSA) Isolated from Burn Patients. Arch. Clin. Infect. Dis. 2020, 15, e91634. [Google Scholar] [CrossRef]
- Tian, Y.; Liang, T.; Zhu, P.; Chen, Y.; Chen, W.; Du, L.; Wu, C.; Wang, P. Label-Free Detection of E. coli O157:H7 DNA Using Light-Addressable Potentiometric Sensors with Highly Oriented ZnO Nanorod Arrays. Sensors 2019, 19, 5473. [Google Scholar] [CrossRef]
- Wu, C.; Li, D.; Jiang, Q.; Gan, N. A Paper-Chip-Based Phage Biosensor Combined with a Smartphone Platform for the Quick and On-Site Analysis of E. coli O157:H7 in Foods. Chemosensors 2023, 11, 151. [Google Scholar] [CrossRef]
- Ateba, C.N.; Mbewe, M. Detection of Escherichia coli O157:H7 virulence genes in isolates from beef, pork, water, human and animal species in the northwest province, South Africa: Public health implications. Res. Microbiol. 2011, 162, 240–248. [Google Scholar] [CrossRef]
- Zhang, D.; Coronel-Aguilera, C.P.; Romero, P.L.; Perry, L.; Minocha, U.; Rosenfield, C.; Gehring, A.G.; Paoli, G.C.; Bhunia, A.K.; Applegate, B. The Use of a Novel NanoLuc -Based Reporter Phage for the Detection of Escherichia coli O157:H7. Sci. Rep. 2016, 6, 33235. [Google Scholar] [CrossRef]
- Abdulhussein, A.A.; Abdulsattar, B.O. Identification and Characterization of a Bacteriophage with Lytic Activity against Multidrug Resistant E. coli. Al-Mustansiriyah J. Sci. 2023, 34, 24–31. [Google Scholar] [CrossRef]
- Ngu, N.; Loc, H.; Nhan, N.; Huan, P.; Anh, L.; Xuan, N. Isolation and characterization of bacteriophages against Escherichia coli isolates from chicken farms. Adv. Anim. Vet. Sci. 2020, 8, 161–166. [Google Scholar] [CrossRef]
- Li, F.; Li, L.; Na, S.; Zhao, J.; Liu, F.; Liu, P.; Li, Y.; Li, M.; Lei, M.; Zhang, D.; et al. Isolation, characterization and genomic analysis of a novel phage IME178 with lytic activity against Escherichia coli. Microb. Pathog. 2023, 179, 106099. [Google Scholar] [CrossRef]
- Ye, Y.; Chen, H.; Huang, Q.; Huang, S.; He, J.; Zhang, J.; Wu, Q.; Li, X.; Hu, W.; Yang, M. Characterization and Genomic Analysis of Novel Vibrio parahaemolyticus Phage vB_VpaP_DE10. Viruses 2022, 14, 1609. [Google Scholar] [CrossRef]
- Zhu, Y.; Shang, J.; Peng, C.; Sun, Y. Phage family classification under Caudoviricetes: A review of current tools using the latest ICTV classification framework. Front. Microbiol. 2022, 13, 1032186. [Google Scholar] [CrossRef]
- Konieczka, T.A.; Wolyniak, M.J. Isolation and characterization of the novel Mycobacterium smegmatis phage Dawnguard. FASEB J. 2022, 36, S1. [Google Scholar] [CrossRef]
- Zaburlin, D.; Quiberoni, A.; Mercanti, D. Changes in environmental conditions modify infection kinetics of dairy phages. Food Environ. Virol. 2017, 9, 270–276. [Google Scholar] [CrossRef]
- Blazanin, M.; Vasen, E.; Jolis, C.V.; An, W.; Turner, P.E. Theoretical validation of growth curves for quantifying phage-bacteria interactions. bioRxiv 2023. [Google Scholar] [CrossRef]
- Park, D.-W.; Lim, G.-y.; Lee, Y.-d.; Park, J.-H. Characteristics of lytic phage vB_EcoM-ECP26 and reduction of shiga-toxin producing Escherichia coli on produce romaine. Appl. Biol. Chem. 2020, 63, 19. [Google Scholar] [CrossRef]
- Tomat, D.; Gonzalez, A.; Aquili, V.; Casabonne, C.; Quiberoni, A. Physicochemical characterization of ten newly isolated phages against the foodborne pathogen Shigella flexneri. J. Food Process. Preserv. 2022, 46, e16818. [Google Scholar] [CrossRef]
- Abd-Allah, I.M.; El-Housseiny, G.S.; Alshahrani, M.Y.; El-Masry, S.S.; Aboshanab, K.M.; Hassouna, N.A. An anti-MRSA phage from raw fish rinse: Stability evaluation and production optimization. Front. Cell. Infect. Microbiol. 2022, 12, 904531. [Google Scholar] [CrossRef] [PubMed]
- Fujimori, S. Gastric acid level of humans must decrease in the future. World J. Gastroenterol. 2020, 26, 6706–6709. [Google Scholar] [CrossRef] [PubMed]
- Vinner, G.K.; Richards, K.; Leppanen, M.; Sagona, A.P.; Malik, D.J. Microencapsulation of Enteric Bacteriophages in a pH-Responsive Solid Oral Dosage Formulation Using a Scalable Membrane Emulsification Process. Pharmaceutics 2019, 11, 475. [Google Scholar] [CrossRef] [PubMed]
- Balestreri, C.; Schroeder, D.C.; Sampedro, F.; Marqués, G.; Palowski, A.; Urriola, P.E.; van de Ligt, J.L.; Yancy, H.F.; Shurson, G.C. Unexpected thermal stability of two enveloped megaviruses, Emiliania huxleyi virus and African swine fever virus, as measured by viability PCR. Virol. J. 2024, 21, 1. [Google Scholar] [CrossRef]
- Kering, K.K.; Zhang, X.; Nyaruaba, R.; Yu, J.; Wei, H. Application of adaptive evolution to improve the stability of bacteriophages during storage. Viruses 2020, 12, 423. [Google Scholar] [CrossRef] [PubMed]
- Hanif, S.; Das, R.; Chavan, B.; Shah, S.; Bajpai, U.; Ahmed, S. P10 Phage-encoded lysins as promising antibacterials against uropathogenic Escherichia coli. JAC-Antimicrob. Resist. 2023, 5, dlac133.014. [Google Scholar] [CrossRef]
- Alexyuk, P.; Bogoyavlenskiy, A.; Alexyuk, M.; Akanova, K.; Moldakhanov, Y.; Berezin, V. Isolation and characterization of lytic bacteriophages active against clinical strains of E. coli and development of a phage antimicrobial cocktail. Viruses 2022, 14, 2381. [Google Scholar] [CrossRef]
- Duc, H.M.; Zhang, Y.; Hoang, S.M.; Masuda, Y.; Honjoh, K.-I.; Miyamoto, T. The use of phage cocktail and various antibacterial agents in combination to prevent the emergence of phage resistance. Antibiotics 2023, 12, 1077. [Google Scholar] [CrossRef]
- Zhao, P.; Meng, X. Characterization of antibacterial activity of lytic bacteriophage PE-1 for biological control of Escherichia coli K88 in vitro. Food Sci. Anim. Resour. 2023, 1, 9240014. [Google Scholar] [CrossRef]
- Jackson, K.; Galipeau, H.; Hann, A.; Coombes, B.; Hosseinidoust, Z.; Verdu, E. A32 phage treatment delays onset of crohn’s-associated E. coli driven colitis in mice colonized with a defined microbiota. J. Can. Assoc. Gastroenterol. 2023, 6, 17–18. [Google Scholar] [CrossRef]
- Wang, Y.; Subedi, D.; Li, J.; Wu, J.; Ren, J.; Xue, F.; Dai, J.; Barr, J.J.; Tang, F. Phage Cocktail Targeting STEC O157:H7 Has Comparable Efficacy and Superior Recovery Compared with Enrofloxacin in an Enteric Murine Model. Microbiol. Spectr. 2022, 10, e00232-22. [Google Scholar] [CrossRef]
- Marongiu, L.; Burkard, M.; Lauer Ulrich, M.; Hoelzle Ludwig, E.; Venturelli, S. Reassessment of Historical Clinical Trials Supports the Effectiveness of Phage Therapy. Clin. Microbiol. Rev. 2022, 35, e00062-22. [Google Scholar] [CrossRef]
- Pessina, B.; Guarnieri, V.; Scarallo, L. Entering the era of phage therapy: A ‘happy hour’ for inflammatory bowel diseases. Allergy 2023, 78, 889–891. [Google Scholar] [CrossRef]
- Nishio, J.; Negishi, H.; Yasui-Kato, M.; Miki, S.; Miyanaga, K.; Aoki, K.; Mizusawa, T.; Ueno, M.; Ainai, A.; Muratani, M.; et al. Identification and characterization of a novel Enterococcus bacteriophage with potential to ameliorate murine colitis. Sci. Rep. 2021, 11, 20231. [Google Scholar] [CrossRef]
- Islam, M.S.; Fan, J.; Pan, F. The power of phages: Revolutionizing cancer treatment. Front. Oncol. 2023, 13, 1290296. [Google Scholar] [CrossRef]
- Suda, T.; Hanawa, T.; Tanaka, M.; Tanji, Y.; Miyanaga, K.; Hasegawa-Ishii, S.; Shirato, K.; Kizaki, T.; Matsuda, T. Modification of the immune response by bacteriophages alters methicillin-resistant Staphylococcus aureus infection. Sci. Rep. 2022, 12, 15656. [Google Scholar] [CrossRef] [PubMed]
- Wortelboer, K.; de Jonge, P.A.; Scheithauer, T.P.M.; Attaye, I.; Marleen Kemper, E.; Nieuwdorp, M.; Herrema, H. Phage-microbe dynamics after sterile faecal filtrate transplantation in individuals with metabolic syndrome: A double-blind, randomised, placebo-controlled clinical trial assessing efficacy and safety. Nat. Commun. 2023, 14, 5600. [Google Scholar] [CrossRef] [PubMed]
- Laforêt, F.; Antoine, C.; Lebrun, S.; Gonza, I.; Goya-Jorge, E.; Douny, C.; Duprez, J.-N.; Scippo, M.-L.; Taminiau, B.; Daube, G.; et al. Impact Assessment of vB_KpnP_K1-ULIP33 Bacteriophage on the Human Gut Microbiota Using a Dynamic In Vitro Model. Viruses 2023, 15, 719. [Google Scholar] [CrossRef] [PubMed]
- Abdelaziz, A.A.; Abo Kamer, A.M.; Nosair, A.M.; Al-Madboly, L.A. Exploring the potential efficacy of phage therapy for biocontrol of foodborne pathogenic extensively drug-resistant Escherichia coli in gastrointestinal tract of rat model. Life Sci. 2023, 315, 121362. [Google Scholar] [CrossRef]
- Azam, A.H.; Sato, K.; Miyanaga, K.; Nakamura, T.; Ojima, S.; Kondo, K.; Tamura, A.; Yamashita, W.; Tanji, Y.; Kiga, K. Selective bacteriophages reduce the emergence of resistant bacteria in bacteriophage-antibiotic combination therapy. Microbiol. Spectr. 2024, 12, e0042723. [Google Scholar] [CrossRef] [PubMed]
- McGee, L.W.; Barhoush, Y.; Shima, R.; Hennessy, M. Phage-resistant mutations impact bacteria susceptibility to future phage infections and antibiotic response. Ecol. Evol. 2023, 13, e9712. [Google Scholar] [CrossRef]
- Leta, A.; Yohannes, M.; Kassa, T. Assessment of therapeutic potential of bacteriophages to control Escherichia coli infection in Swiss mice model. Ethiop. J. Appl. Sci. Technol. 2017, 8, 73–83. [Google Scholar]

| Bacteria (Number) | Serogroup | Phage | |||||||||||||||
|---|---|---|---|---|---|---|---|---|---|---|---|---|---|---|---|---|---|
| SPEC1 | SPEC 2 | SPEC 3 | SPEC 4 | SPEC 5 | SPEC 6 | SPEC7 | LPEC8 | SPEC9 | SPEC10 | SPEC11 | SPEC12 | SPEC13 | SPEC14 | SPEC15 | SPEC16 | ||
| E. coli (n = 18) | O157:H7 | 11 | 9 | 8 | 13 | 11 | 10 | 11 | 10 | 9 | 6 | 9 | 5 | 18 | 7 | 11 | 13 |
| E. coli (n = 17) | non-O157:H7 | 9 | 10 | 6 | 8 | 9 | 4 | 6 | 8 | 11 | 3 | 5 | 2 | 17 | 2 | 6 | 7 |
| Bacteria | Strains | Serotype | Drug Resistance | SPEC13/ Spot Test | SPEC13/ EOP | Sources |
|---|---|---|---|---|---|---|
| E. coli | ATCC 43890 | O157:H7 | / | + | 1 | ATCC (Host) |
| E. coli | KCJ4201 | O157:H7 | / | + | 1 | [3] |
| E. coli | EDL933 | O157:H7 | / | + | 1 | [3] |
| E. coli | DH5α | / | / | + | 1 | L.S. |
| E. coli | BL21 | / | / | + | 1 | L.S. |
| E. coli | Trans 10 | / | / | + | 1 | L.S. |
| E. coli | FEC6 | O157:H7 | / | + | 1 | L.S. |
| E. coli | FEC9 | O157:H7 | CIP/AMP | + | 1 | L.S. |
| E. coli | FEC10 | O157:H7 | CIP/AMP | + | 1 | L.S. |
| E. coli | FEC16 | / | / | + | 1 | L.S. |
| E. coli | FEC17 | / | / | + | 1 | L.S. |
| E. coli | FEC29 | / | / | + | 1 | L.S. |
| E. coli | FEC28 | / | / | + | 0.9 | L.S. |
| E. coli | FEC14 | O157:H7 | CIP/AMP/KAN/PLC | + | 0.9 | L.S. |
| E. coli | FEC24 | / | / | + | 0.85 | L.S. |
| E. coli | FEC3 | O157:H7 | / | + | 0.8 | L.S. |
| E. coli | FEC15 | O157:H7 | CIP/AMP/KAN/STR | + | 0.8 | L.S. |
| E. coli | FEC12 | O157:H7 | CIP/AMP/GEN/KAN | + | 0.8 | L.S. |
| E. coli | FEC22 | / | / | + | 0.8 | L.S. |
| E. coli | FEC1 | O157:H7 | / | + | 0.7 | L.S. |
| E. coli | FEC2 | O157:H7 | / | + | 0.7 | L.S. |
| E. coli | FEC13 | O157:H7 | CIP/AMP/KAN/CHL | + | 0.7 | L.S. |
| E. coli | FEC4 | O157:H7 | / | + | 0.6 | L.S. |
| E. coli | FEC26 | / | / | + | 0.6 | L.S. |
| E. coli | FEC5 | O157:H7 | / | + | 0.5 | L.S. |
| E. coli | FEC7 | O157:H7 | / | + | 0.4 | L.S. |
| E. coli | FEC11 | O157:H7 | CIP/AMP/GEN/KAN/STR/CHL/PCS | + | 0.4 | L.S. |
| E. coli | FEC18 | / | / | + | 0.4 | L.S. |
| E. coli | FEC8 | O157:H7 | / | + | 0.3 | L.S. |
| E. coli | FEC19 | / | / | + | 0.3 | L.S. |
| E. coli | FEC20 | / | / | + | 0.3 | L.S. |
| E. coli | FEC21 | / | / | + | 0.2 | L.S. |
| E. coli | FEC23 | / | / | + | 0.2 | L.S. |
| E. coli | FEC25 | / | / | + | 0.1 | L.S. |
| E. coli | FEC27 | / | / | + | 0.1 | L.S. |
| S. Enteritidis | ATCC 13076 | / | / | - | 0 | ATCC |
| S. Enteritidis | SGSC 4901 | / | / | - | 0 | L.S. |
| S. Typhimurium | ATCC 14028 | / | / | - | 0 | ATCC |
| S. Typhimurium | ATCC 13311 | / | / | - | 0 | ATCC |
| Staphylococcus aureus | ATCC 29213 | / | / | - | 0 | ATCC |
| Listeria monocytogenes | ATCC 19115 | / | / | - | 0 | ATCC |
| Bacteroides fragilis | ATCC 43858 | / | / | - | 0 | ATCC |
| Pseudomonas aeruginosa | ATCC 7853 | / | / | - | 0 | ATCC |
| Fusobacterium | ATCC 10953 | / | / | - | 0 | ATCC |
Disclaimer/Publisher’s Note: The statements, opinions and data contained in all publications are solely those of the individual author(s) and contributor(s) and not of MDPI and/or the editor(s). MDPI and/or the editor(s) disclaim responsibility for any injury to people or property resulting from any ideas, methods, instructions or products referred to in the content. |
© 2024 by the authors. Licensee MDPI, Basel, Switzerland. This article is an open access article distributed under the terms and conditions of the Creative Commons Attribution (CC BY) license (https://creativecommons.org/licenses/by/4.0/).
Share and Cite
Islam, M.S.; Fan, J.; Suzauddula, M.; Nime, I.; Pan, F. Isolation and Characterization of Novel Escherichia coli O157:H7 Phage SPEC13 as a Therapeutic Agent for E. coli Infections In Vitro and In Vivo. Biomedicines 2024, 12, 2036. https://doi.org/10.3390/biomedicines12092036
Islam MS, Fan J, Suzauddula M, Nime I, Pan F. Isolation and Characterization of Novel Escherichia coli O157:H7 Phage SPEC13 as a Therapeutic Agent for E. coli Infections In Vitro and In Vivo. Biomedicines. 2024; 12(9):2036. https://doi.org/10.3390/biomedicines12092036
Chicago/Turabian StyleIslam, Md. Sharifull, Jie Fan, Md Suzauddula, Ishatur Nime, and Fan Pan. 2024. "Isolation and Characterization of Novel Escherichia coli O157:H7 Phage SPEC13 as a Therapeutic Agent for E. coli Infections In Vitro and In Vivo" Biomedicines 12, no. 9: 2036. https://doi.org/10.3390/biomedicines12092036
APA StyleIslam, M. S., Fan, J., Suzauddula, M., Nime, I., & Pan, F. (2024). Isolation and Characterization of Novel Escherichia coli O157:H7 Phage SPEC13 as a Therapeutic Agent for E. coli Infections In Vitro and In Vivo. Biomedicines, 12(9), 2036. https://doi.org/10.3390/biomedicines12092036

